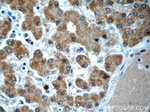
TMEM59 Antibody in Immunohistochemistry (Paraffin) (IHC (P))

Search
Proteintech
TMEM59 Polyclonal Antibody
{{$productOrderCtrl.translations['antibody.pdp.commerceCard.promotion.promotions']}}
{{$productOrderCtrl.translations['antibody.pdp.commerceCard.promotion.viewpromo']}}
{{$productOrderCtrl.translations['antibody.pdp.commerceCard.promotion.promocode']}}: {{promo.promoCode}} {{promo.promoTitle}} {{promo.promoDescription}}. {{$productOrderCtrl.translations['antibody.pdp.commerceCard.promotion.learnmore']}}
产品信息
24134-1-AP
种属反应
宿主/亚型
分类
类型
抗原
偶联物
形式
浓度
规格
纯化类型
保存液
内含物
保存条件
运输条件
产品详细信息
Immunogen sequence: MAAPKGSLW VRTQLGLPPL LLLTMALAGG SGTASAEAFD SVLGDTASCH RACQLTYPLH TYPKEEELYA CQRGCRLFSI CQFVDDGIDL NRTKLECESA CTEAYSQSDE QYACHLGCQN QLPFAELRQE QLMSLMPKMH LLFPLTLVRS FWSDMMDSAQ SFITSSWTFY LQADDGKIVI FQSKPEIQYA PHLEQEPTNL RESSLSKMSS DLQMRNSQAH RNFLEDGESD GFLRCLSLNS GWILTTTLVL SVMVLLWICC ATVATAVEQY VPSEKLSIYG DLEFMNEQKL NRYPASSLVV VRSKTEDHEE AGPLPTKVNL AHSEI (1-324 aa encoded by BC016374)
靶标信息
Processing of the amyloid precursor protein (APP) by two different proteases, called alpha- and beta-secretase, is a central regulatory event in the generation of the amyloid beta peptide (Abeta), which has a key role in Alzheimer disease (AD) pathogenesis. TMEM59, a Golgi-localized protein, modulates the O-glycosylation and complex N-glycosylation steps occurring during the Golgi maturation of several proteins such as APP, BACE1, SEAP or PRNP. It inhibits APP transport and shedding.
仅用于科研。不用于诊断过程。未经明确授权不得转售。
生物信息学
蛋白别名: dendritic cell factor 1; Liver membrane-bound protein; LMBP; RP4-758J24.2; Transmembrane protein 59; unnamed protein product
基因别名: C1orf8; DCF1; HSPC001; PRO195; TMEM59; UNQ169; UNQ169/PRO195
UniProt ID: (Human) Q9BXS4
Entrez Gene ID: (Human) 9528